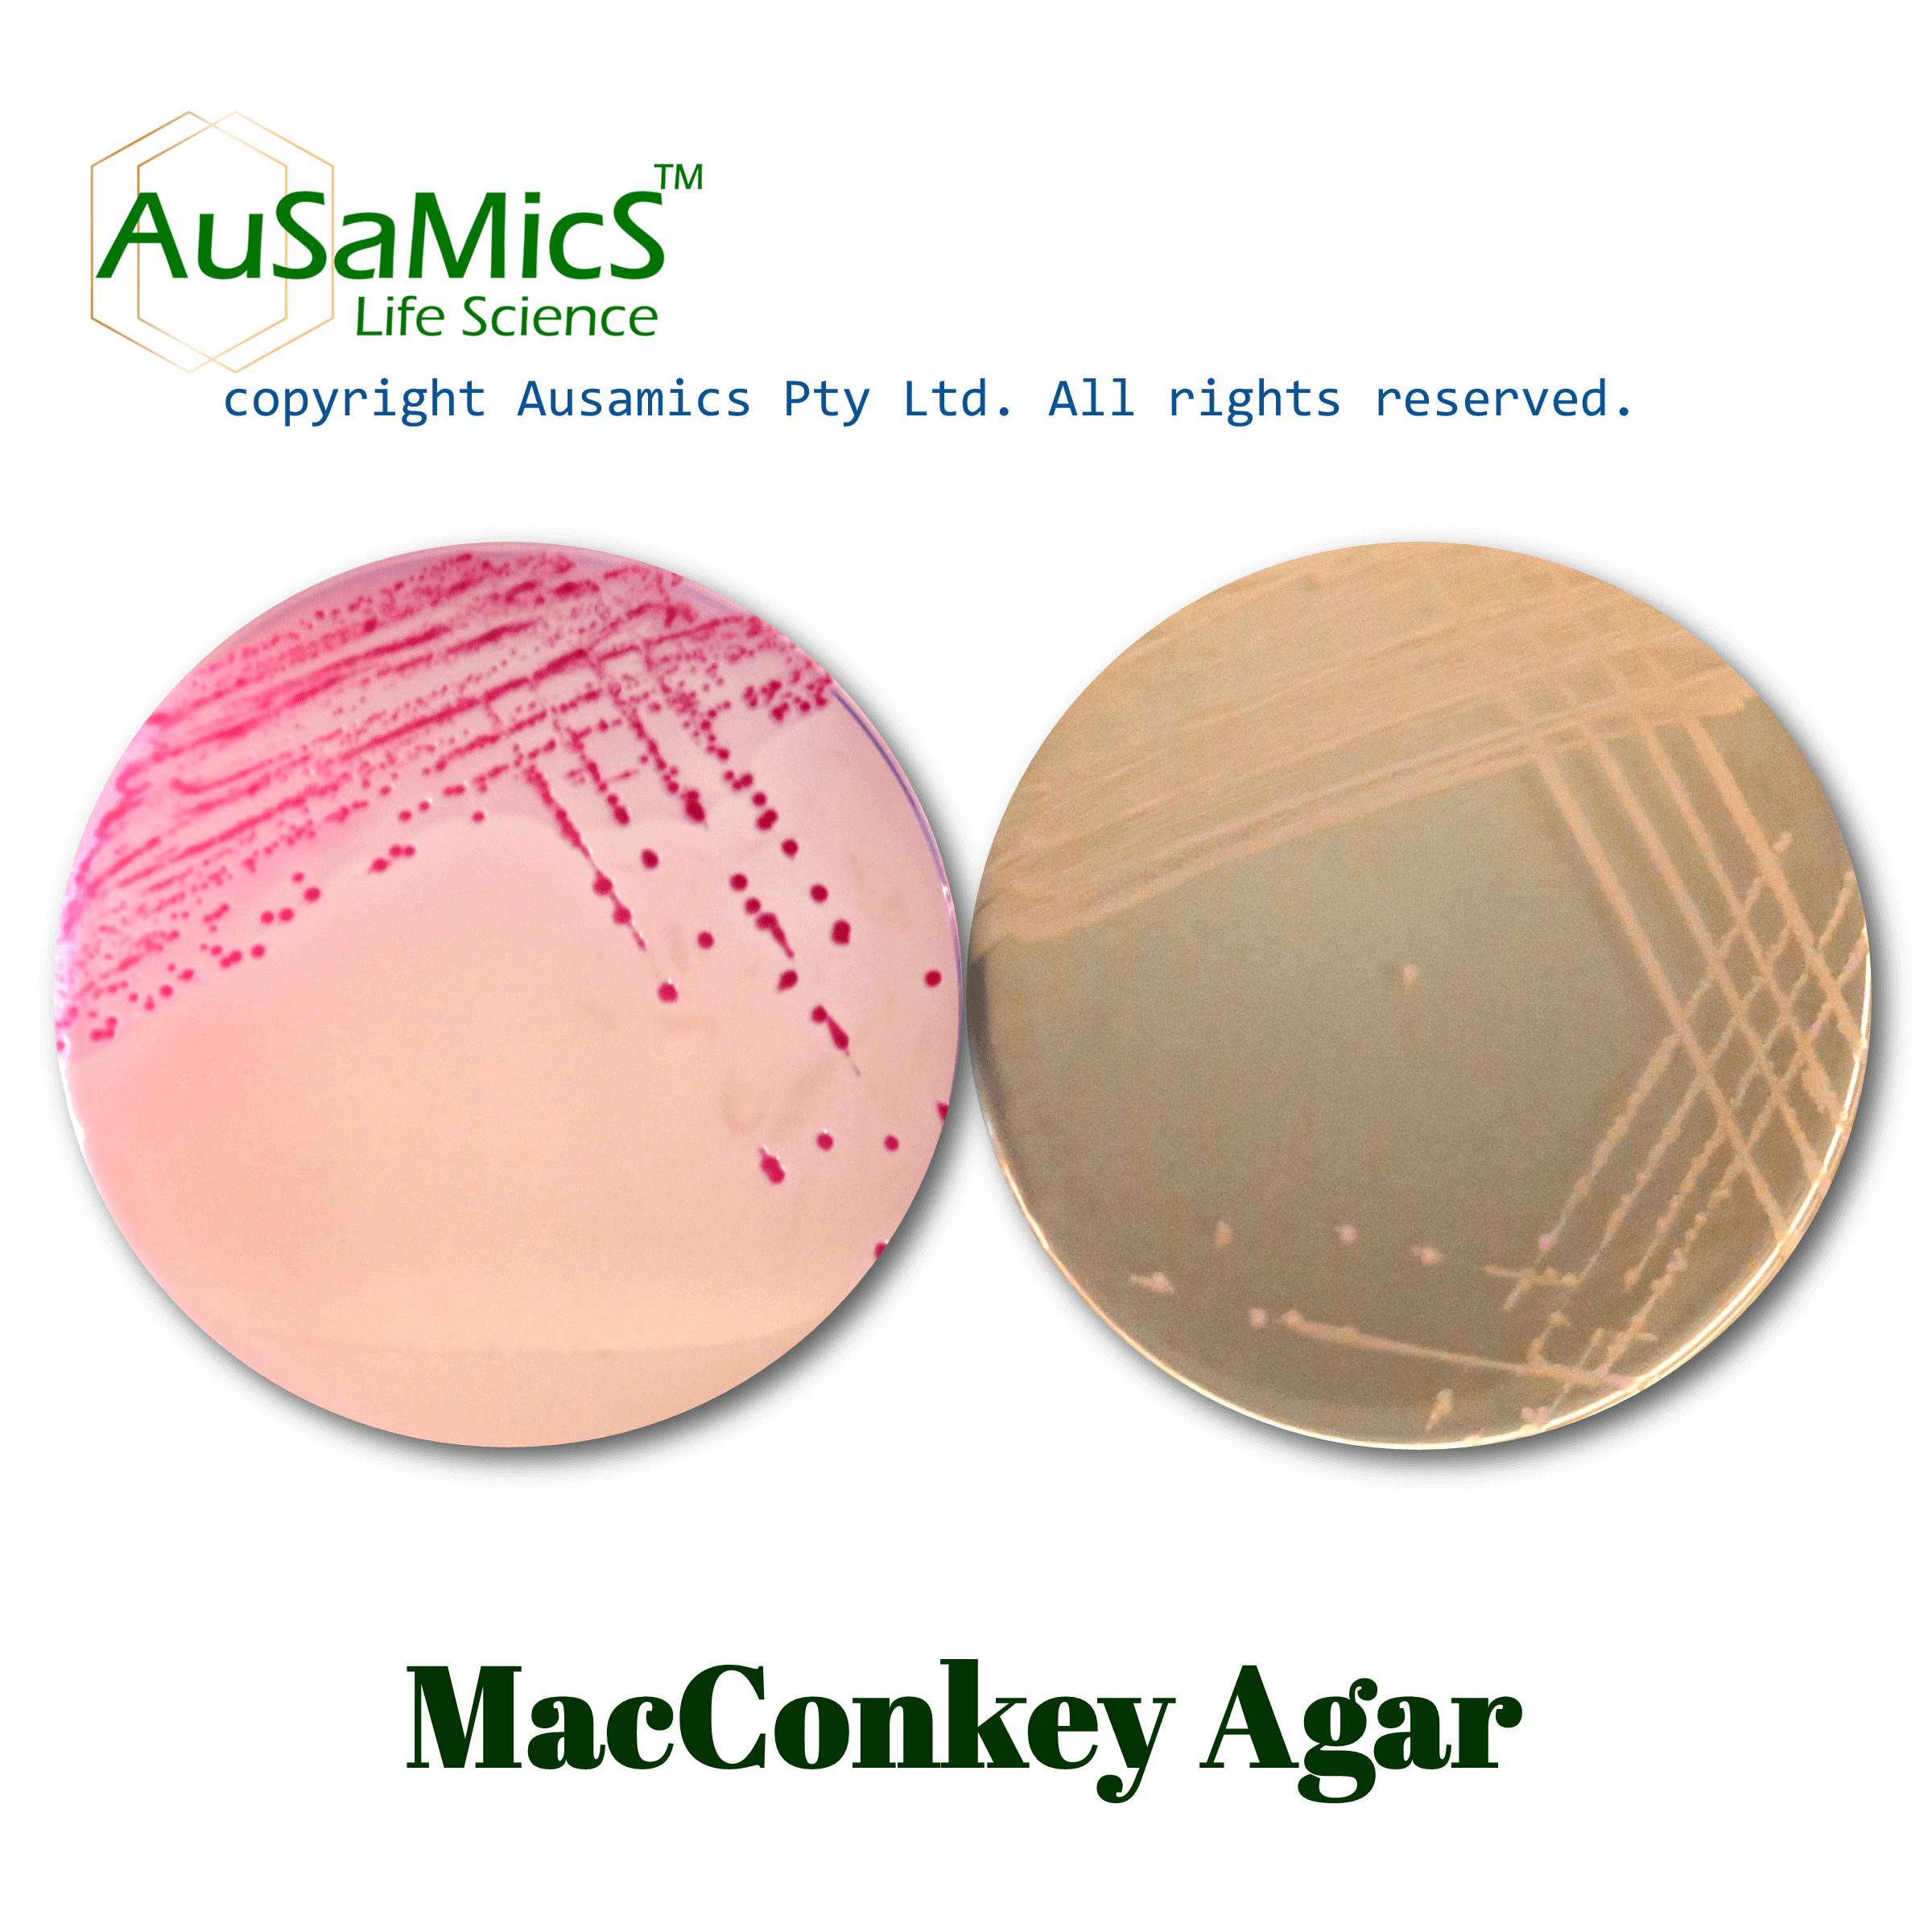
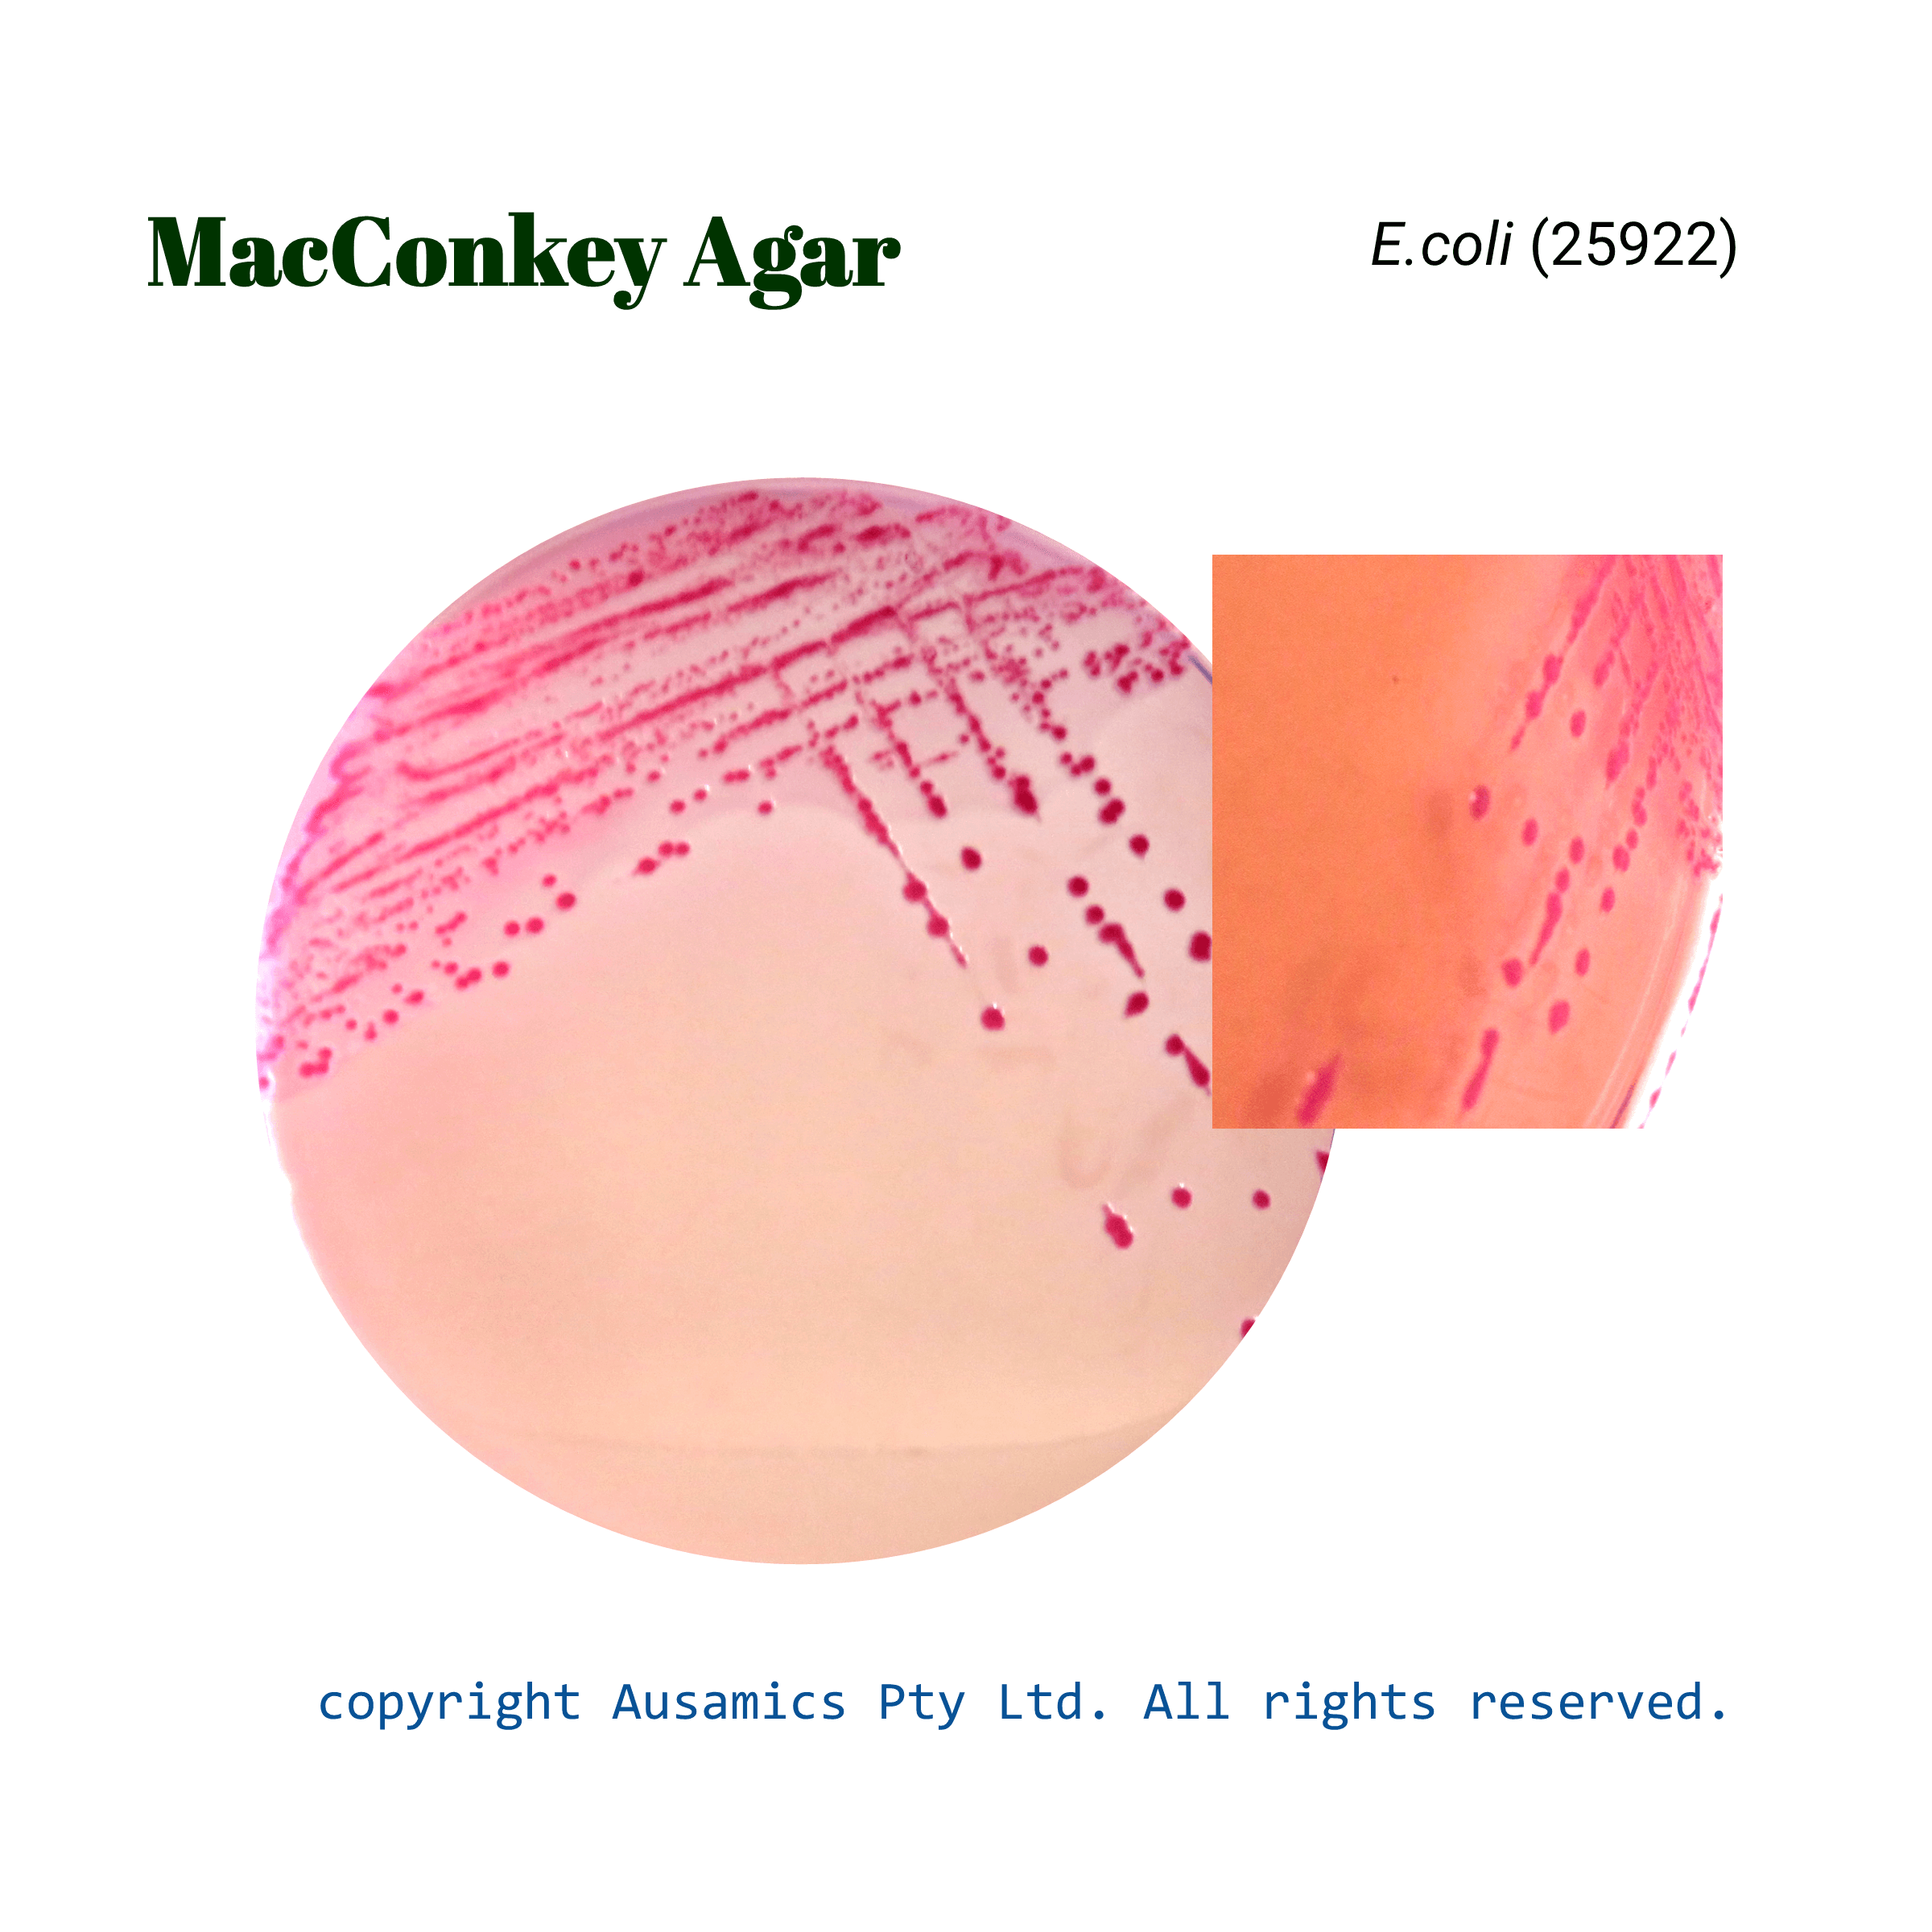
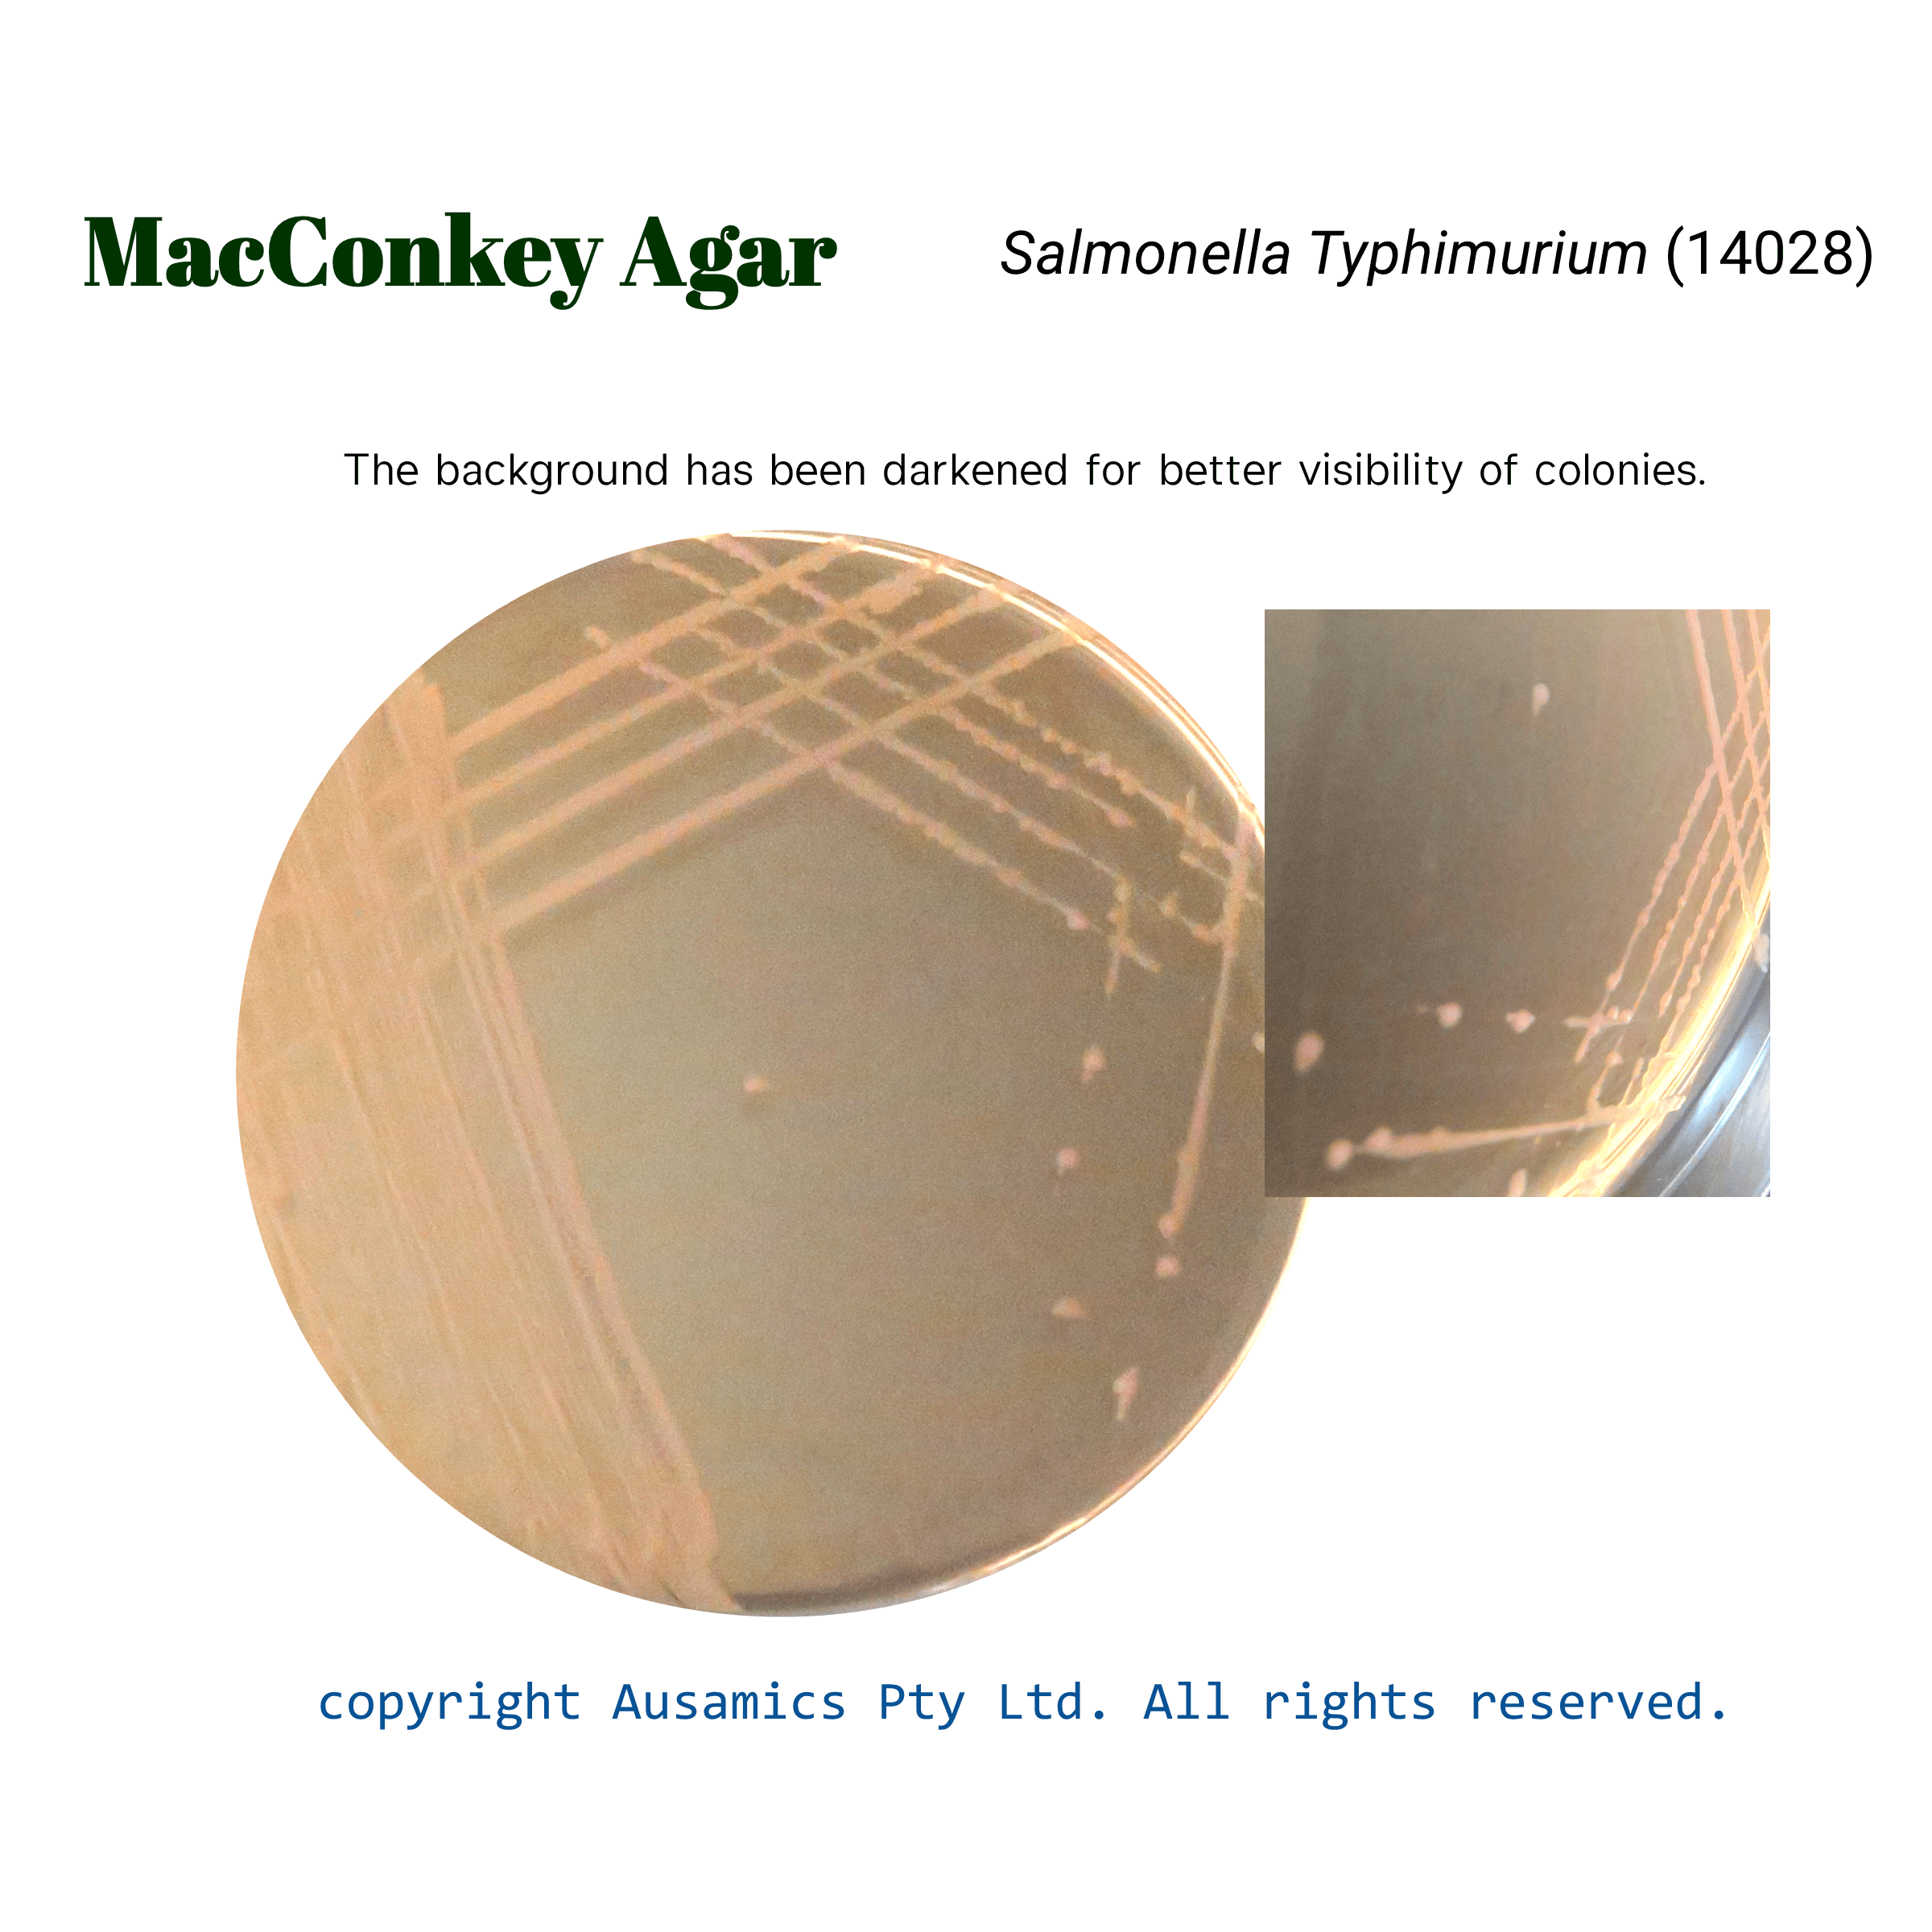
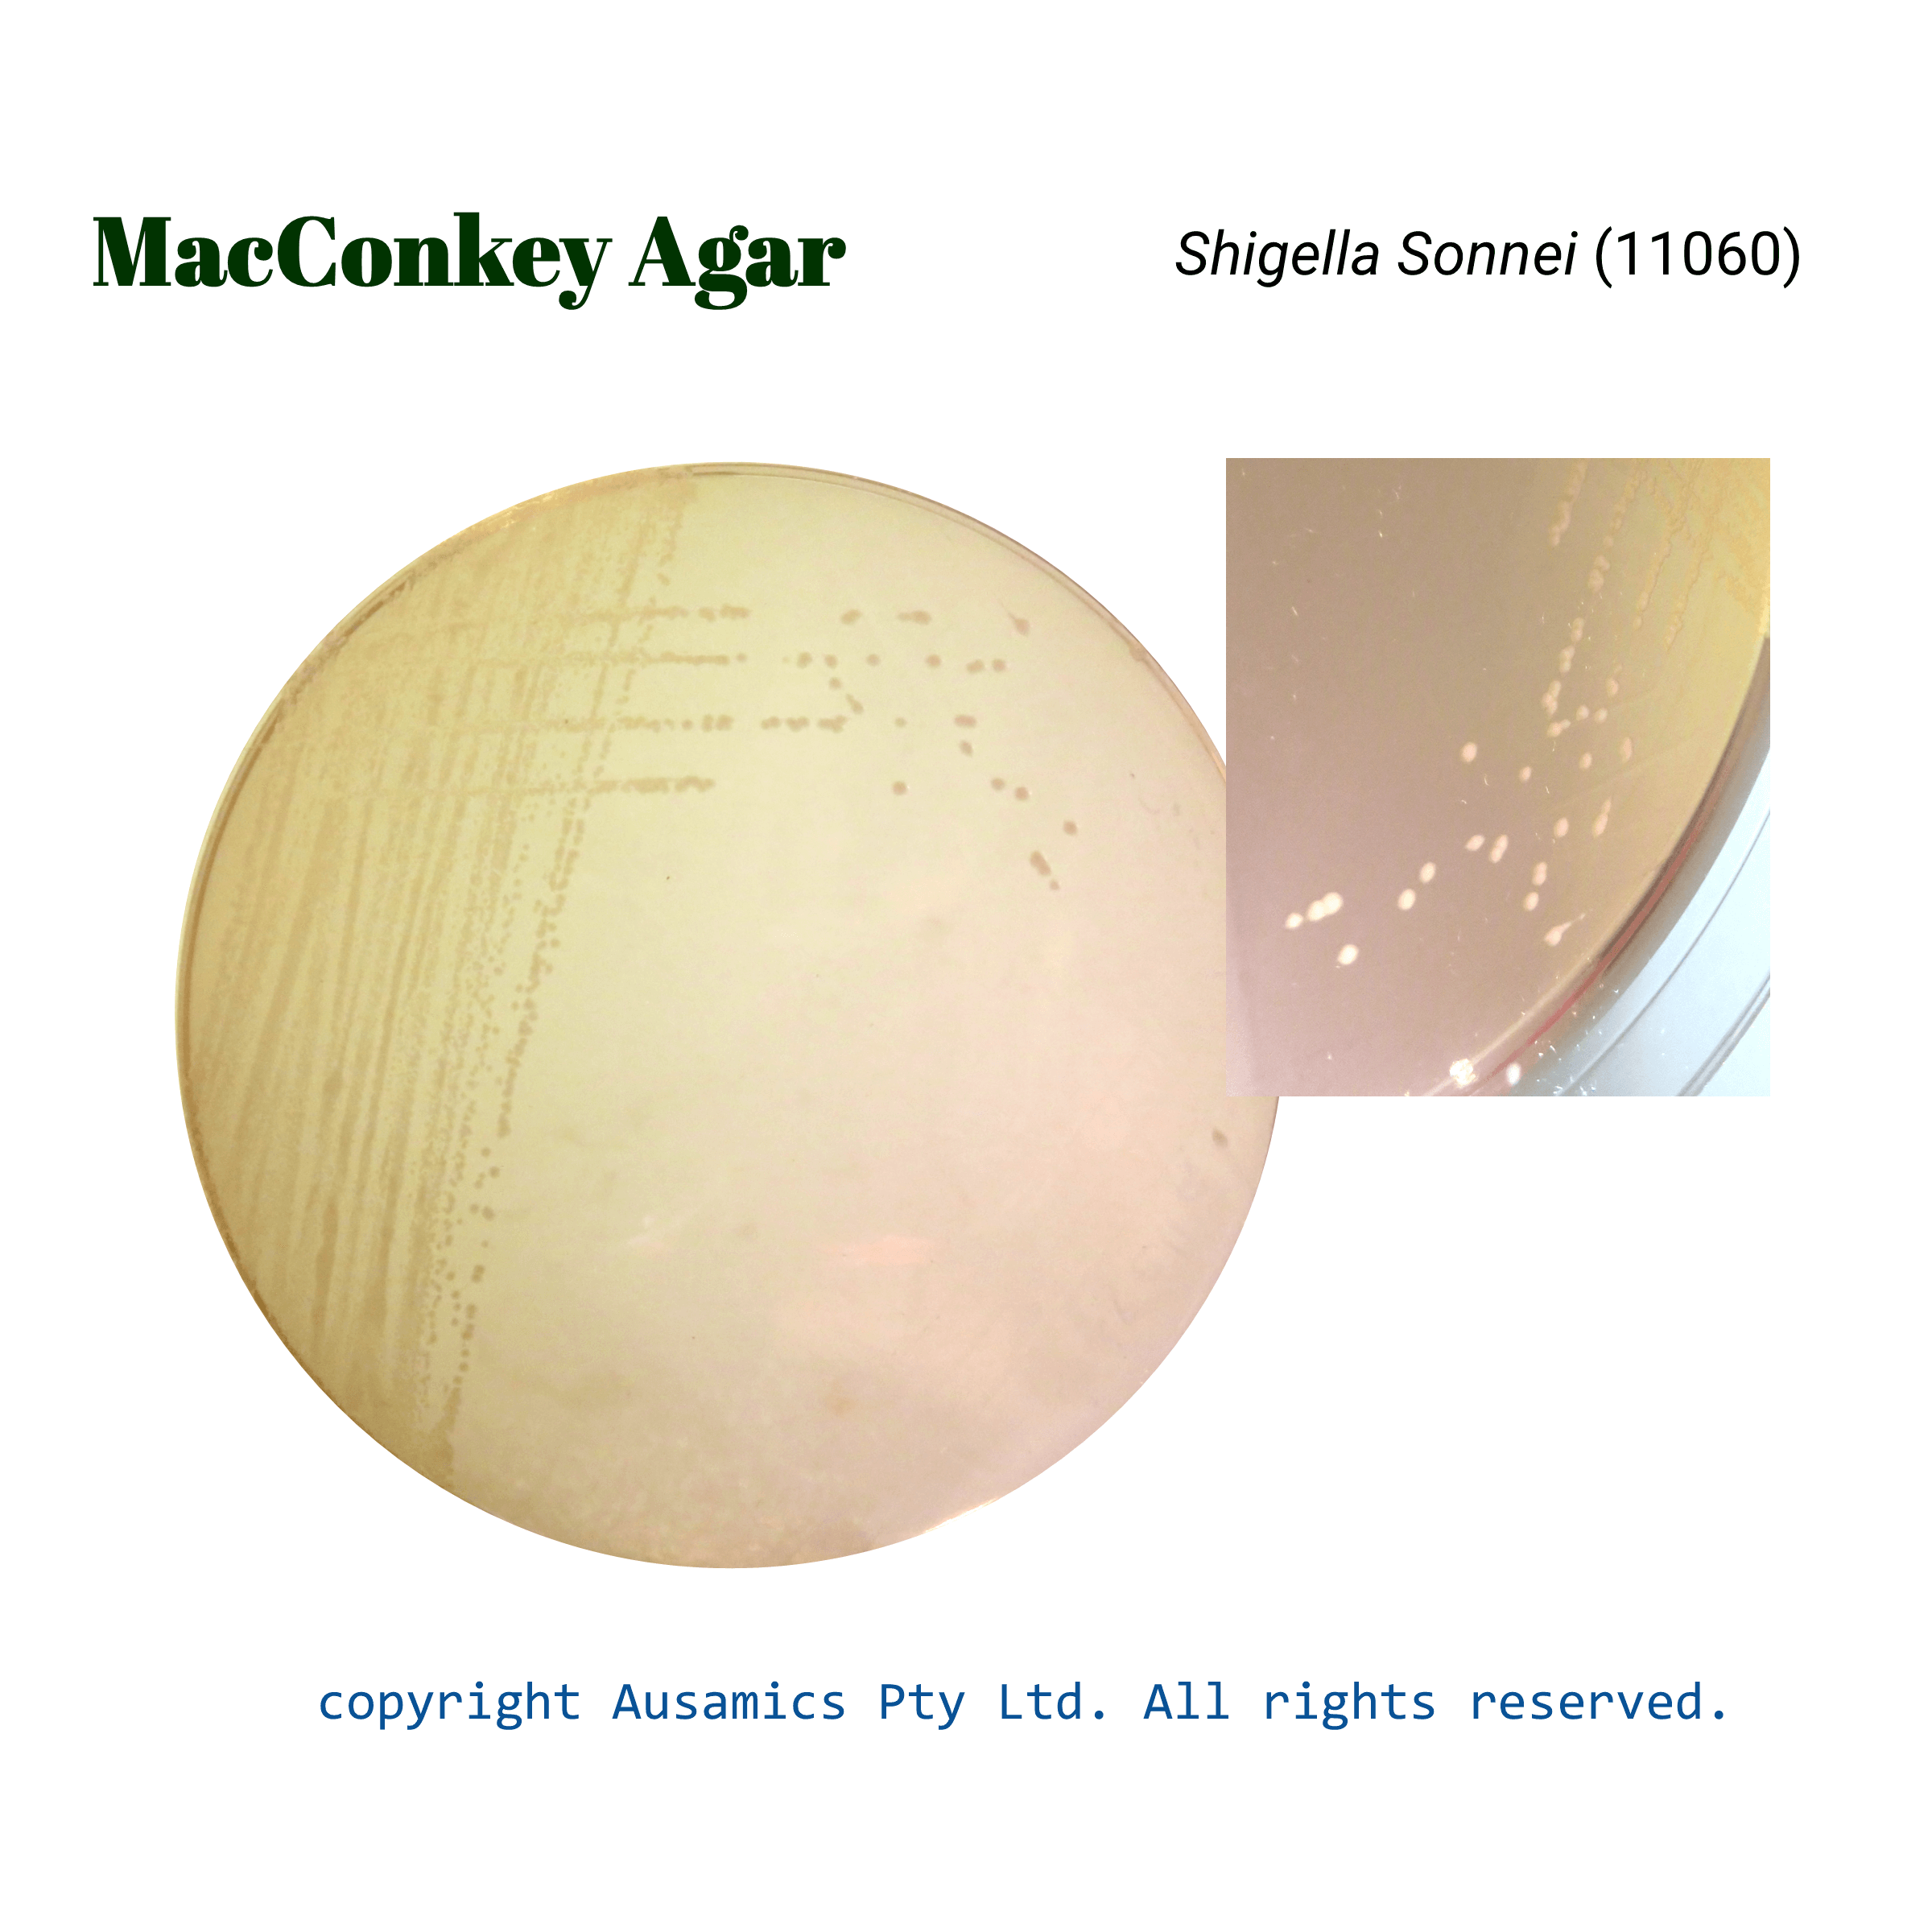

MacConkey Agar
Used for detection and isolation of gram-negative organisms from industrial sources like clinical, dairy, food, water, pharmaceutical, cosmetic.
- Description
- Composition
- Quality Control
- Microbial Test Results
Gram-negative enteric bacteria can be isolated and differentiated using MacConkey agar, a selective and differential culture medium. By adding bile salts and crystal violet, the medium becomes selective by preventing the growth of Gram-positive bacteria. The fermentable carbohydrate lactose and the pH indicator neutral red help to distinguish between lactose fermenters and non-fermenters. The fermentation of lactose produces acid, which causes the pH indicator to change color and causes pink colonies to form. Producing acid also causes bile salts precipitation which can be seen as halos around colonies. In clinical, food, and water microbiology, MacConkey agar is frequently utilized for the isolation and preliminary identification of Enterobacteriaceae.
Storage
Keep the container at 15-30 °C and prepared medium at 2-8 °C.
| Composition | gr/L |
| Peptone from Casein | 17 |
| Peptone from Meat | 3 |
| Lactose | 10 |
| Bile Salts Mixture | 1.5 |
| Sodium Chloride | 5 |
| Neutral Red | 0.03 |
| Crystal Violet | 0.001 |
| Agar | 13.5 |
| Final pH at 25°C | 7.1 ± 0.2 |
| Dehydrated Appearance | Beige, free-flowing, homogeneous. |
| Prepared Appearance | Red with purplish tinge colored, clear to slightly opalescent. |
| Reaction of 5.0% Solution at 25°C | pH 7.1 ± 0.2 |
| incubate at 35 ± 2 °C for 18 to 24 hours. E. coli ATCC 25922 should be incubated for 40 to 48 hours. E. coli ATCC 8739 must be inoculated in duplicate and incubate one plate at 30 – 35 °C for 18 to 48 hours. Incubate the other one at 35 – 37 °C for 18 to 72 hours. | |||
| Organism (ATCC) | Recovery | Colony color | Bile PPT. |
| Escherichia coli (25922) | Good | Pink to red | + |
| Escherichia coli (8739) | Growth (30-35 °C) | Pink to red | + |
| Escherichia coli (8739) | Growth (35-37 °C) | Pink to red | + |
| Enterococcus faecalis (29212) | inhibition | – | – |
| Salmonella Typhimurium (14028) | Good | Colorless | – |
| Proteus mirabilis (12453) | Good | Colorless | – |